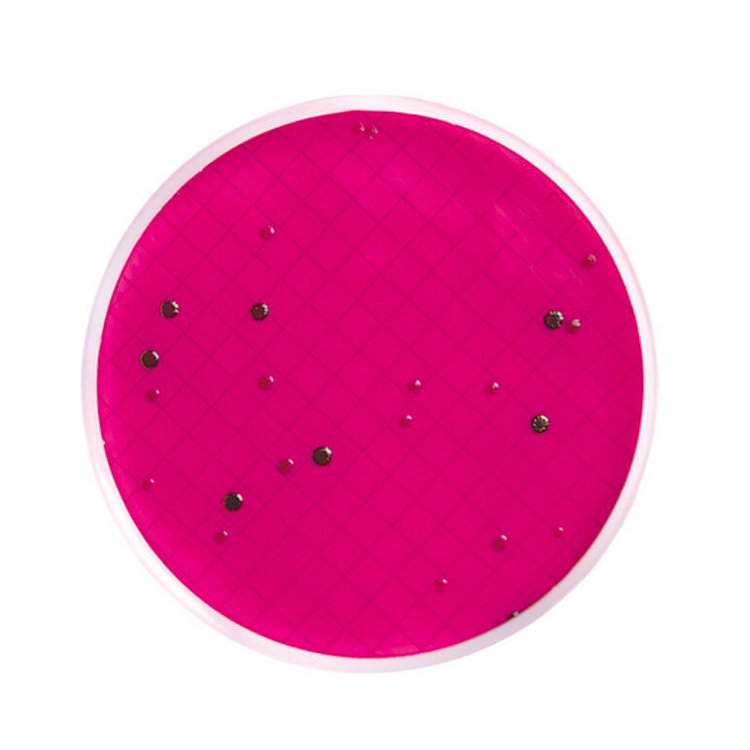

Milliflex过滤系统可对制药企业中的制药用水和过滤的原辅料以及最终产品进行微生物限度检验。另外,还广泛应用于公共场所用水、电子行业中DI水、包装饮用水、酒类、果汁和其他软饮以及再生产过程中用到的液体原料的微生物负荷进行检验。
• 卫生级材料便于清洁
• 内置消毒程序方便设备的清洁和灭菌
产品性能参数:
Milliflex 方法与国际上现行的标准完全一致
• 使用55mm或47mm带网格预先灭菌的无菌过滤膜
• 提供100ml和250ml的无菌漏斗,方便用户使用
• 漏斗的表面采用疏水处理以提高细菌的恢复生长率
• 漏斗内部光滑无划痕和死角
• 独特的封口技术防止膜侧生长,尤其适用于抑菌性样品的检査
• 食品级的多聚物材质,对微生物生长没有抑制作用
• 提供抛弃型和可多次使用的滤杯
• 用于过滤的是具有验证证书的0.45μm的微孔过滤膜
Milliflex Plus全自动过滤系统
简单易用的操作维护方式
• 一体式自动化设计,操作简单
• 配备无菌滤杯和预制培养皿
• 内置检验装置
样品处理时间更短
• 过滤100毫升纯水仅需10秒钟
• 内置隔膜泵,操作简单无风险
三种过滤模式可供选择
自动模式 - 选择预设程序进行自动过滤
稀释模式 - 设定程序并按照此程序进行过滤
手动模式 - 按照操作者意愿手动操作进行过滤
丰富的Milliflex® Plus 用实验耗材
• 过滤后无需处理膜片
• 滤膜与培养基可完美贴合在一起
• 出厂前全部完整性测试
• 每批均进行恢复生长率测试
• 密封技术防止样品侧漏,优化冲洗流程
• 满足法规要求
• 提供100ml和250ml的无菌漏斗,方便用户选择
• 漏斗表面采用疏水处理以提高微生物的恢复生长率
• 漏斗内部光滑,无划痕和死角
• 独特的封口技术防止发生侧漏和微生物边缘生长,尤其适用于抗生素样品的检查
• 食品级的多聚物材质,对微生物生长无抑制作用
| 技术参数 |
| 滤膜 | MEC或PVDF |
| 滤杯 | 聚乙烯 |
| 培养皿 | 聚乙烯丙烯腈(SAN) |
| 过滤面积 | 17.3cm2 |
| 滤杯体积 | 100ml,250ml |
| 订货信息 |
| 产品 | 货号 | 数量/包装 |
| Milliflex标准滤杯单元 | ||
| 0.45μm, 白色, 带网格,MCE, 100ml滤杯 | MXHAWG124 | 24 |
| 0.45μm, 黑色, 带网格,MCE, 100ml滤杯 | MXHABG124 | 24 |
| 0.22μm, 白色, 带网格,MCE, 100ml滤杯 | MXGSWG124 | 24 |
| 0.45μm, 白色, 无网格,PVDF, 100ml滤杯 | MXHVWP124 | 24 |
| 0.45μm, 白色, 带网格,MCE, 250ml滤杯 | MXHAWG224 | 24 |
| Milliflex滤膜转移辅助设备 | ||
| MilliSnap系统 | MILSNAP01 | 1 |
| Milliflex® 预制培养基 | ||
| Baird Parker Agar 贝尔德-帕克琼脂 | MXSMBPA48 | 48cassettes |
| Cetrimide Agar 绿脓杆菌培养基 | MXSMCET48 | 48cassettes |
| Heterotrophic Plate Count Agar 异氧菌平板计数培养基 | MXSMHPC48 | 48cassettes |
| KF Strep Agar KF链球菌琼脂基础培养基 | MXSMKFS48 | 48cassettes |
| m Endo LES Agar 膜过滤法远藤氏琼脂 | MXSMEND48 | 48cassettes |
| Plate Count Agar 平板计数培养基 | MXSMPCA48 | 48cassettes |
| Pseudomonas lsolation Agar 假单胞菌分离培养基 | MXSMPIA48 | 48cassettes |
| R2A Agar R2A 琼脂 | MXSMCRA48 | 48cassettes |
| Sabouraud Dextrose Agar 沙氏葡萄糖琼脂 | MXSMCSD48 | 48cassettes |
| Sabouraud Dextrose Agar with Chloramphenicol 沙氏葡萄糖琼脂加入氯霉素 | MXSMCSP48 | 48cassettes |
| Tryptic Soy Agar 胰蛋白胨大豆琼脂 | MXSMCTS48 | 48cassettes |
| Tryptic Soy Agar with Polysorbate 80 and Lecithin 胰蛋白胨大豆琼脂加入中和剂 | MXSMTLP48 | 48cassettes |
| Tryptone Glucose Extract Agar 胰蛋白胨葡萄糖琼脂 | MXSMTGE48 | 48cassettes |
| Yeast and Mold Agar 酵母霉菌培养基 | MXSMCYM48 | 48cassettes |
| Cetrimide Agar with Naladixic Acid 绿脓杆菌培养基加入萘啶酸 | MXSMCET24 | 24cassettes |
| MacConkey Agar 麦康凯培养基 | MXSMSMCM24 | 24cassettes |
| Milliflex®标准无菌空培养皿 | ||
| 液体培养基用培养皿 | MXLMC0120 | 120 |
| 固体培养基用培养皿 | MXSMC0120 | 120 |

客服1
客服1